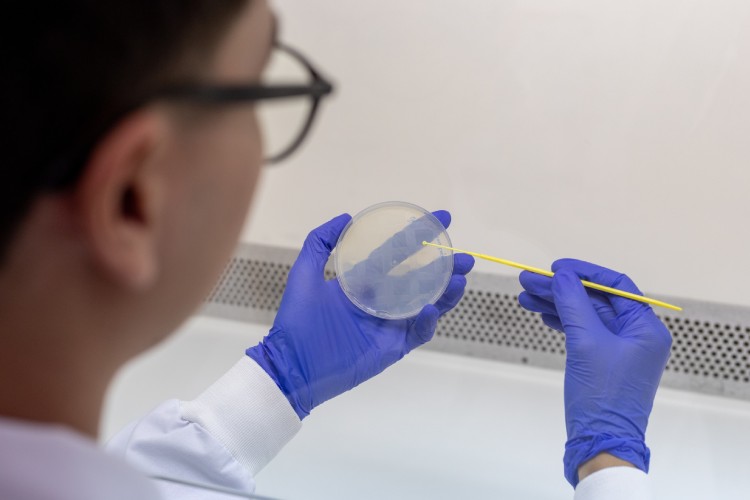

Reportagem: Natasha Pinelli
Fotos: Renato Rodrigues
É falando sobre assuntos científicos complexos que o biomédico Maxy Hiro Matsusue Umbelino, de 22 anos, se sente confortável e fica mais extrovertido. Já na escola, o estudante via a timidez que o acompanha desde a infância ir embora quando se posicionava na frente da sala de aula para apresentar seus trabalhos de ciências, compartilhando com empolgação contagiante informações sobre plantas briófitas, pteridófitas, gimnospermas e angiospermas, ou sobre o microuniverso das células.
Na faculdade de biomedicina, a capacidade de facilitar a compreensão de temas difíceis levou Maxy a ser indicado pelos professores para ser monitor, ajudando os colegas com dificuldades nas diversas matérias do curso. “Sempre fui uma pessoa muito tímida, até com certa dificuldade em fazer amizades; mesmo sendo assim, fechado, conseguia me sair bem nessas situações explanatórias”, conta o jovem cientista, que acabou de ingressar no curso de especialização em Toxinas de Interesse em Saúde da Escola Superior do Instituto Butantan (ESIB).
Esse é o segundo curso que o estudante faz na ESIB. Em 2024, foi aluno da especialização em Biotecnologia para a Saúde: Vacinas e Biofármacos, e desenvolveu uma pesquisa sobre como diferentes alimentos bacterianos afetam o comportamento, a fisiologia e a longevidade do Caenorhabditis elegans – verme com potencial de ser utilizado como organismo modelo em pesquisas, devido à sua simplicidade e facilidade de manutenção. O trabalho foi conduzido no Laboratório de Parasitologia do Instituto Butantan e contou com a orientação do biólogo e tecnologista Fernando Luiz Kamitani.

Infância de encantamento com a ciência
Natural de Juquiá, cidade com cerca de 15 mil habitantes no Vale do Ribeira paulista, filho de uma professora de Educação Física e de um comerciante – atualmente o pai mora no estado de Rondônia –, Maxy cresceu em um ambiente onde o conhecimento era valorizado. Aos 5 anos, o pequeno já dava indícios de que seguiria no rumo da ciência: ficava hipnotizado ao assistir documentários de canais como National Geographic, Animal Planet e Discovery, e tinha uma certa fixação pela vida marinha, com foco especial nos tubarões. Quando questionado sobre o clássico filme “Tubarão”, de 1975, dirigido por Steven Spielberg, ele é taxativo: “É trash, mas adoro.”
Ao lado do irmão, hoje formado em medicina, Maxy assistia a todos os experimentos do Manual do Mundo, canal de ciência do YouTube encabeçado por Iberê Thenório e Mari Fulfaro. Dentre as diversas experiências caseiras que os meninos tentaram reproduzir, um vulcão com magma feito à base de vinagre fez história. “Fizemos a maior bagunça, o cheiro perdurou por dias! Lembro da minha mãe ter ficado muito brava”, diverte-se, recordando a “travessura científica”.
Com a matriarca da família, o jovem desenvolveu o gosto pelo xadrez. Entre os 9 e os 17 anos, treinou sério o jogo: participou de diversos campeonatos regionais do Vale do Ribeira e da Baixada Santista, e até de uma competição internacional na cidade de Registro (SP). Da experiência de jogar com mestres estrangeiros, Maxy se lembra de ter aprendido a lidar com a frustração diante das seguidas derrotas, e do sentimento de respeito ao ouvir aquilo que os mais experientes tinham a lhe ensinar – assim como das aulas de inglês, claro. A recordação daqueles tempos divertidos está em uma parede cheia de medalhas e nos troféus dispostos pela casa da mãe, além de se refletir na paciência e no raciocínio lógico necessários para lidar com a carreira científica.

Do sonho de ser professor à paixão pela pesquisa
Inspirado pela mãe e por seu professor de ciências no Ensino Fundamental, Maxy pensou em prestar biologia e seguir carreira acadêmica, para no futuro trabalhar como professor do Ensino Médio ou Superior. Chegada a época do vestibular, racionalizou sobre sua inibição e acabou optando pela biomedicina. “No fundo, sempre tive vontade de contribuir com o desenvolvimento da saúde, mas por conta da minha timidez, passei longe da medicina. Acabei escolhendo biomedicina pois não precisaria lidar diretamente com pessoas e poderia ficar nos bastidores, como no laboratório”, conta.
Durante a faculdade, no Centro Universitário do Vale do Ribeira, Maxy teve seu primeiro contato com a pesquisa por meio da Iniciação Científica. Seu projeto estava atrelado a uma pesquisa maior, que incluía o desenvolvimento de pomadas e hidrogéis para o tratamento de osteoartrose no joelho, e uma de suas responsabilidades era fornecer uma série de explicações e esclarecimentos aos voluntários envolvidos no processo. “Foi essa experiência que me mostrou o caminho da pesquisa e me fez ter a certeza por onde queria seguir. Sempre me senti confortável em compartilhar conhecimento; mas, com a pesquisa, entendi que somos nós que produzimos esse valor”, observa.
Após concluir a graduação, no final de 2023, Maxy foi aprovado no curso de especialização da ESIB. No início de 2024, colocou seus sonhos em uma mala, despediu-se da pequena Juquiá, onde quase não circulam ônibus, e mudou-se para a capital paulista. Na cidade de São Paulo, teve que aprender na marra a se deslocar, utilizando as inúmeras linhas de ônibus e metrô, além de acostumar-se com o trânsito caótico.

No Laboratório de Parasitologia do Butantan, foi carinhosamente recebido por seu orientador Fernando Luiz Kamitani – com quem compartilha uma série de características, entre elas a introspecção, a ascendência japonesa e o gosto por animes – e ouviu falar, pela primeira vez, o nome científico que se tornaria objeto de seu fascínio: Caenorhabditis elegans, ou C. elegans para os íntimos.
“Minha experiência aqui no laboratório foi um divisor de águas. Comecei do zero, li e estudei muito, para só então desenhar uma linha de pesquisa, planejar e realizar os experimentos e, posteriormente, trabalhar os resultados. Foi um caminho muito prazeroso”, afirma. Para Fernando, o desempenho de Maxy foi acima da média. “Eu apresentei o modelo e ofereci todo o suporte, mas o desenho experimental foi todo dele. Isso não é qualquer um que faz”, avalia o orientador.
Em seu trabalho de especialização, Maxy buscou entender como a alimentação dos C. elegans com diferentes linhagens de Escherichia coli afeta o desenvolvimento do verme. No experimento, o biomédico comparou a cepa OP50 – comumente usada em laboratório para esse fim – e a NA22. Os resultados mostraram que os vermes alimentados com NA22 tinham maior tamanho corporal, melhor movimentação e período fértil prolongado; porém, viviam menos tempo. Já os que se alimentavam de OP50 viviam muito mais, embora a maioria não preferisse essa bactéria. “Concluímos que a dieta bacteriana interfere diretamente no desenvolvimento do verme, seja em sua fisiologia, morfologia ou comportamento. Cada cepa favorece uma característica específica, e isso pode contribuir para uma manutenção mais eficaz dos C. elegans em laboratório”, explica Maxy.
Conhecidos também como nematoides – vermes microscópicos, encontrados na camada de material orgânico que se acumula no solo conhecida como serrapilheira –, eles têm alto potencial para serem utilizados como modelo biológico em pesquisa, devido ao seu acelerado tempo de desenvolvimento e estrutura corporal transparente, que facilita a observação das estruturas físicas e anatômicas. Quando consolidada, a plataforma dos C. elegans poderá contribuir com os chamados três “Rs” da experimentação animal: reduce, refine e replace – ou seja, reduzir o uso de animais mais complexos (como os roedores) em rotinas de pesquisa e refinar os experimentos, tornando-os cada vez mais eficazes até serem substituídos ou não mais utilizados.
Na XXIII Reunião Científica Anual do Butantan, evento em que a comunidade científica do Instituto apresenta seus principais destaques de pesquisa, Maxy conquistou o segundo lugar na categoria “Especialização” com o estudo desenvolvido no Laboratório de Parasitologia. Além de ter se destacado durante a apresentação, realizada para uma plateia repleta de especialistas e pesquisadores do Instituto, o aluno teve o reconhecimento de seus pares na sessão de pôsteres. “Muitas pessoas vieram falar comigo e me perguntar detalhes do estudo por conta da apresentação. Foi um baita reconhecimento”, comemora.

Apresentação de Maxy durante a Reunião Científica Anual do Butantan, em 2024
Vida pessoal e sonhos de um jovem cientista
Quando não está no Laboratório de Parasitologia observando seus pequenos vermes no estereomicroscópio (ou lupa), Maxy gosta de aproveitar o tempo livre em casa assistindo a filmes de “sagas de gosto duvidoso”, segundo ele, como “Crepúsculo”, ou animes. Também adora jogar World of Warcraft, RPG em que diversos jogadores interagem online, e “desenferrujar” seus estratagemas no xadrez.
Fora de casa, seu negócio é se aventurar pelas ruas do bairro da Liberdade na companhia da namorada Larissa. O casal, que se conheceu no laboratório do Butantan, curte experimentar os diferentes sabores da culinária asiática e visitar perfumarias para “experimentar” produtos e “adivinhar” as notas presentes na composição – um hobby para lá de diferente. Curioso em conhecer mais sobre suas raízes e antepassados, o estudante também tem planos de visitar o Japão.
Apesar disso, os planos mais ambiciosos estão ligados ao futuro científico: além de se dedicar ao seu segundo curso de especialização na ESIB, a meta é ingressar no mestrado a fim de complementar e aperfeiçoar a linha de pesquisa com o C. elegans. “Quero conquistar o título de doutor. Não me falta vontade de chegar lá. Dizem que a curiosidade matou o gato, mas no meu caso, é essa necessidade constante em saber sempre mais que me move todos os dias.”



